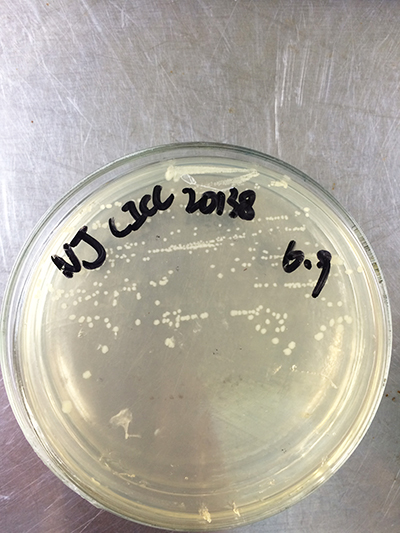

2015-07-29
作者:通威

凝結(jié)芽孢桿菌革蘭氏染色照片
近期,通過錨定凝結(jié)芽孢桿菌基因組、應(yīng)用比較基因組等生物信息學(xué)分析技術(shù),篩選出特異基因,設(shè)計(jì)引物,多重PCR擴(kuò)增,經(jīng)一系列優(yōu)化試驗(yàn),成都通威水產(chǎn)科技有限公司成功建立凝結(jié)芽孢桿菌快速檢測(cè)技術(shù),已申報(bào)發(fā)明專利一項(xiàng)。
凝結(jié)芽孢桿菌在培養(yǎng)基上的形態(tài)特征
凝結(jié)芽孢桿菌具有普通乳酸菌的益生保健功能,還能耐受飼料制粒的高溫,從而在水產(chǎn)上應(yīng)用較多。目前市場(chǎng)上該類產(chǎn)品缺乏規(guī)范的管理及科學(xué)的檢測(cè)方法,產(chǎn)品質(zhì)量參差不齊,存在以普通芽孢桿菌冒充凝結(jié)芽孢桿菌的現(xiàn)象,非專業(yè)人士極難察覺。成都通威水產(chǎn)科技有限公司一直致力于應(yīng)用分子生物學(xué)手段進(jìn)行益生菌特異性檢測(cè)技術(shù)研究,因而充分利用現(xiàn)有平臺(tái)與技術(shù)優(yōu)勢(shì)進(jìn)行技術(shù)攻關(guān),成功建立凝結(jié)芽孢桿菌檢測(cè)技術(shù)。該技術(shù)具有靈敏度高、重現(xiàn)性好、易操作等優(yōu)點(diǎn)。傳統(tǒng)鑒定方法需耗費(fèi)至少1周,甚至更長時(shí)間,新建立的檢測(cè)技術(shù)僅需4小時(shí),限度低至1.6×104 cfu/mL仍可獲得特異性檢測(cè)結(jié)果。

實(shí)驗(yàn)員正在進(jìn)行試驗(yàn)
該檢測(cè)技術(shù)的成功建立將促進(jìn)凝結(jié)芽孢桿菌優(yōu)良性價(jià)比產(chǎn)品的篩選,對(duì)指導(dǎo)相關(guān)產(chǎn)品應(yīng)用具有非常重要的意義。成都通威水產(chǎn)科技有限公司將繼續(xù)致力于益生菌的檢測(cè)技術(shù)和相關(guān)產(chǎn)品研發(fā)。
